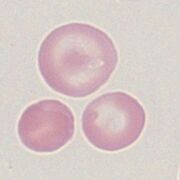

Target cells
From haematologyetc.co.uk
Derivation: cells resemble targets with a central “bulls eye”
Appearance
Erythrocytes in which the area of pallor contains a central accumulation of haemoglobin giving the appearance of a "target".
Image 1: The target cell is distinctive with a central “bullseye” accumulation of haemoglobin lying in the area of central pallor of the cell. Although shown here as a normal erythrocyte target forms often arise in abnormal erythrocytes with hypochromia or added elements.
Image 2: The context of the target cell is very important – here the cell is lies within the normal size range and there is an accompanying irregularly contracted cell as may be seen in HbC disease; other common contexts may be microcytosis (liver disease) or microcytic hypochromic cells (thalassaemia or iron deficiency)
Significance
Target cells are abnormal, but are not associated with a single specific disease type. Therefore, always look for the context: where target cells are the dominant abnormal form look for macrocytosis that may imply liver disease; or if MCV is normal or low consider a haemoglobinopathy (HbC, D or E). If the target cell is part of a spectrum of abnormal morphological forms then look at other cell types present.
Pathobiology
The most accepted mechanism for this morphological form is an “excess of membrane compared to haemoglobin content” (the opposite of the spherocyte) – in this case the “thin” cell adopts the shape of “hat with a brim” when relaxed in the capillary circulation, when this dries onto a glass slides the typical “target appearance” is formed. The imbalance between haemoglobin content and membrane area may arise as a result of reduced haemoglobin content (particularly thalassaemia) or excess membrane resulting from disturbed plasma lipid (e.g. liver disease). Excess membrane may also arise in hyposplenism since the normal “red cell conditioning” in spleen fails to remove excess membrane as the erythrocyte matures. A different mechanism may underlie the formation of these cells in haemoglobinopathy (e.g. Haemoglobin C or D) where the altered solubility of the abnormal haemoglobin may play a significant role.
Pitfalls
The form is distinctive, and rarely mistaken for other appearances. The key instead is to interpret the cell correctly. Ask are target cells the dominant form (implying particular haemoglobinopathy types or liver disease)? Or are they part of a spectrum of abnormal red cell forms (e.g. features of thalassaemia or splenectomy)? Then consider target cell size and context.
Causes
| Abnormal haemoglobin or abnormal haemoglobin synthesis |
|---|
| Reduced haemoglobin formation: Thalassaemias or Iron deficiency: Generally, target cells are more frequent in thalassaemia than in iron deficiency. In some thalassaemia e.g. HbE they are very frequent. Hypochromia and microcytosis will be present. |
| Haemoglobinopathy: HbC, HbD and HbS . Target cells (together with irregularly contacted cells) are a major feature of HbC and HbD diseases, for HbS (or compound haemoglobinopathies e.g. HbSC) the target cells simply form part of the overall morphological syndrome. Cells will be normocytic or microcytic. |
| Causes related to membrane lipid |
| Lipid disturbance e.g. related to liver disease: e.g. hepatic cirrhosis, alcohol. The excess membrane lipid produces macrocytic erythrocytes. |
| Hyposplenic states. Reduced splenic conditioning results in excess membrane lipid. Other features of hyposplenism will be present. |
| Inherited deficiency of lecithin-cholesterol acyl transferase. A very rare (but characteristic) inherited cause of target cells |
Clinical Examples
Clinical Image 1:Norrmocytic target cells and a range of normal cells. This film is from a post-splenectomy patient – note the single cell with a blue inclusion (Howell Jolly body). Clinical condition: hyposplenismNorrmocytic target cells and a range of normal cells. This film is from a post-splenectomy patient – note the single cell with a blue inclusion (Howell Jolly body). Clinical condition: hyposplenism
'Clinical Image 2: Normocytic/microcytic target cells. Note also the many irregularly contracted cells; the targe cells are similar in size to the nucleus of the small lymphocyte. There is only one well-formed target cell although many other cells can be regarded as being partial target forms on closer inspection. Clinical condition: haemoglobin C.
Clinical Image 3: Hypochromiv and microctic target cells. Here the context is of marked hypochromia – often difficult to assess with target cells but in this case very marked. There are also nucleated red cells and features of fragility and previous splenectomy. Clinical condition thalassaemia intermedia.